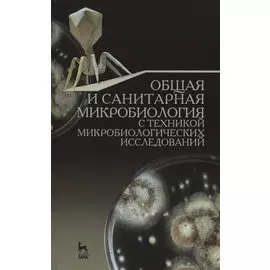
Общая и санитарная микробиология с техникой микробиологических исследований. Учебное пособие

Вы находитесь на странице "учебники по технологии лань". Здесь представлены товары российских и зарубежных компаний в количестве 1119 шт., включая популярные мировые бренды. Доставка из интернет-магазинов возможна в такие города России как: Москва, Санкт-Петербург, Новосибирск, Екатеринбург, Казань, Нижний Новгород, Челябинск, Красноярск, Самара, Уфа, Ростов-на-Дону, Омск, Краснодар, Воронеж, Волгоград, Пермь и др. Каталог включает как доступные по цене товары, так и продукцию люксового сегмента.
-
 Лань3589 ₽
Лань3589 ₽Энциклопедия деревообработки. Учебное пособие для вузов | Приведены краткие сведения в форме статей (всего 119 статей), термины и определения по технологии различных подотраслей деревообрабатывающей п...
-
 Лань1047 ₽
Лань1047 ₽Практические основы производства органической продукции. Учебное пособие для вузов | Учебное пособие содержит теоретический материал, контрольные вопросы и задания для самостоятельного выполнения. Пре...
-
 Лань1356 ₽1057 ₽-22%
Лань1356 ₽1057 ₽-22%Основы реабилитации в акушерстве и гинекологии. Учебное пособие | В учебном пособии в доступной форме изложены материалы о лечебных физических факторах, механизме их действия на женский организм, осно...
-
 Лань2713 ₽2115 ₽-22%
Лань2713 ₽2115 ₽-22%Оборудование и инструмент деревообрабатывающих и плитных производств. Учебно-справочное пособие | В этой книге автор стремился по возможности полно отразить весь спектр оборудования деревообработки, р...
-
 Лань2713 ₽2115 ₽-22%
Лань2713 ₽2115 ₽-22%Аэрогидродинамика и тепломассообмен насадочных аппаратов. Монография | Колонные аппараты насадочного типа широко используются в химической технологии, в энергетической и других отраслях промышленности...
-
 Лань2123 ₽1592 ₽-25%
Лань2123 ₽1592 ₽-25%Практикум по скотоводству и технологии производства молока и говядины. Учебн. пос., 1-е изд. | В практикуме изложены основные показатели молочной и мясной продуктивности крупного рогатого скота, раскр...
-
 Лань2595 ₽2023 ₽-22%
Лань2595 ₽2023 ₽-22%Инженерное обустройство территорий. Учебное пособие | Рассмотрены теоретические основы инженерного обустройства незастроенных и застроенных территорий. В первой части «Инженерное обустройство незастро...
-
 Лань599 ₽387 ₽-35%
Лань599 ₽387 ₽-35%Технология изготовления лекарственных форм. Твердые лекарственные формы. Учебное пособие | Данное пособие содержит краткое изложение теоретических основ изготовления и свойств твердых лекарственных фо...
-
![Средства автоматики гидро- и пневмосистем. Учебн. пос., 1-е изд.]() Лань2241 ₽1747 ₽-22%
Лань2241 ₽1747 ₽-22%Средства автоматики гидро- и пневмосистем. Учебн. пос., 1-е изд. | Книга содержит описание и основы расчета гидравлических, пневматических, электрогидравлических, электропневматических элементов автом...
-
![Технология получения свекловичного сахара. Современные технологии и оборудование фильтрования соков и сиропов свеклосахарного производства]() Лань1019 ₽689 ₽-32%
Лань1019 ₽689 ₽-32%Технология получения свекловичного сахара. Современные технологии и оборудование фильтрования соков и сиропов свеклосахарного производства | Пособие разработано в соответствии с рабочей программой МДК...
-
![Оценка надежности технологического процесса изготовления литых деталей. Монография]() Лань2831 ₽2207 ₽-22%
Лань2831 ₽2207 ₽-22%Оценка надежности технологического процесса изготовления литых деталей. Монография | В книге впервые на основе проведенных исследований установлена взаимосвязь конструкции детали, процессов ее кристал...
-
![Моделирование сигналов и систем. Дифференциальные, дискретные и цифровые модели динамических систем. Учебное пособие]() Лань2241 ₽1747 ₽-22%
Лань2241 ₽1747 ₽-22%Моделирование сигналов и систем. Дифференциальные, дискретные и цифровые модели динамических систем. Учебное пособие | Рассмотрены методология и технология компьютерного моделирования непрерывных, дис...
-
![Технология изготовления лекарственных форм: фармацевтическая несовместимость ингредиентов в прописях]() Лань1592 ₽1241 ₽-22%
Лань1592 ₽1241 ₽-22%Технология изготовления лекарственных форм: фармацевтическая несовместимость ингредиентов в прописях | Согласно типовым профессионально-должностным требованиям специалист аптеки обязан знать затруднит...
-
![Модели и методы исследования информационных систем. Монография]() Лань2929 ₽2051 ₽-29%
Лань2929 ₽2051 ₽-29%Модели и методы исследования информационных систем. Монография | Дается систематическое изложение моделей представления данных и знаний, в том числе рассматриваются классические модели баз данных и мо...
-
![Технология кондитерских изделий]() Лань2005 ₽1504 ₽-24%
Лань2005 ₽1504 ₽-24%Технология кондитерских изделий | Представлена классификация кондитерских изделий с использованием установленных стандартами терминов и определений в области готовых изделий и полуфабрикатов кондитерс...
-
![Инфокоммуникационные системы и сети. Учебник]() Лань5781 ₽4507 ₽-22%
Лань5781 ₽4507 ₽-22%Инфокоммуникационные системы и сети. Учебник | В пособии после изложения сущности гибридных приложений на основе Apache Cordova (ранее PhoneGap) и NativeScript, их особенностей, достоинств и недостатк...
-
![Технология безалкогольных напитков]() Лань2123 ₽1592 ₽-25%
Лань2123 ₽1592 ₽-25%Технология безалкогольных напитков | Учебное пособие подготовлено в соответствии с современными достижениями науки, направленными на совершенствование технологии безалкогольных напитков, организацию и...
-
![Технология и оборудование для производства и обработки древесных плит. Уч. Пособие]() Лань1474 ₽1149 ₽-22%
Лань1474 ₽1149 ₽-22%Технология и оборудование для производства и обработки древесных плит. Уч. Пособие | Рассмотрены технология и машины для производства древесно-стружечных плит (ДСтП), плит с ориентированной стружкой (...
-
![Прикладная гидрогазодинамика.]() Лань1096 ₽855 ₽-21%
Лань1096 ₽855 ₽-21%Прикладная гидрогазодинамика. | В пособии представлены теоретические основы, расчетные зависимости, справочные данные и задачи (с примерами решения и числовыми ответами) по прикладной гидрогазодинамик...
-
![Введение в гибридные технологии разработки мобильных приложений. Учебное пособие для СПО, 2-е изд., стер.]() Лань1989 ₽1368 ₽-31%
Лань1989 ₽1368 ₽-31%Введение в гибридные технологии разработки мобильных приложений. Учебное пособие для СПО, 2-е изд., стер. | В пособии после изложения сущности гибридных приложений на основе Apache Cordova (ранее Phon...
-
![Экспертиза кормов и кормовых добавок. Учебное пособие 4-е изд. испр. и доп.]() Лань1474 ₽1149 ₽-22%
Лань1474 ₽1149 ₽-22%Экспертиза кормов и кормовых добавок. Учебное пособие 4-е изд. испр. и доп. | Книга включает наиболее полный учебно-справочный материал по вопросам качества и безопасности кормов и кормовых добавок дл...
-
![Химия и технология полимеров. Получение полимеров методами поликонденсации и полимераналогичных превращений. Лабораторный практикум]() Лань3421 ₽2667 ₽-22%
Лань3421 ₽2667 ₽-22%Химия и технология полимеров. Получение полимеров методами поликонденсации и полимераналогичных превращений. Лабораторный практикум | Лабораторный практикум представляет собой руководство для выполнен...
-
![Введение в сварочные технологии: Учебное пособие.]() Лань1669 ₽1137 ₽-31%
Лань1669 ₽1137 ₽-31%Введение в сварочные технологии: Учебное пособие. | В книге приведены сведения о свариваемых конструкционных материалах, механизме образования неразъемных соединений конструкционных материалов и основ...
-
![Практикум по решению задач школьной математики: применение Web-квест технологии. Учебно-методическое]() Лань683 ₽533 ₽-21%
Лань683 ₽533 ₽-21%Практикум по решению задач школьной математики: применение Web-квест технологии. Учебно-методическое | Учебно-методическое пособие предназначено для выполнения обучающимися заданий на занятиях практик...
-
![Технология производства яиц и мяса птицы на промышленной основе. Учебное пособие]() Лань1519 ₽1064 ₽-29%
Лань1519 ₽1064 ₽-29%Технология производства яиц и мяса птицы на промышленной основе. Учебное пособие | В учебном пособии обобщены достижения науки и практики в производстве яиц и мяса всех видов сельскохозяйственной птиц...
-
![Технология производства продукции овцеводства. Учебное пособие для СПО]() Лань1769 ₽1379 ₽-22%
Лань1769 ₽1379 ₽-22%Технология производства продукции овцеводства. Учебное пособие для СПО | В учебном пособии представлены комплексные материалы, формирующие глубокие знания о технологии производства шерсти и баранины. ...
-
![Основы построения инфокоммуникационных сетей и систем. Учебное пособие для СПО]() Лань2123 ₽1655 ₽-22%
Лань2123 ₽1655 ₽-22%Основы построения инфокоммуникационных сетей и систем. Учебное пособие для СПО | В учебном пособии рассмотрены основные принципы построения современных цифровых и аналоговых инфокоммуникационных систе...
-
![Схемотехника и расчет бестрансформаторных усилителей с обратными связями. Учебное пособие]() Лань2359 ₽1839 ₽-22%
Лань2359 ₽1839 ₽-22%Схемотехника и расчет бестрансформаторных усилителей с обратными связями. Учебное пособие | В учебном пособии рассматриваются вопросы построения и расчета схем высококачественных бестрансформаторных з...
-
![Традиции и инновации в технологии безалкогольных напитков. Монография]() Лань1887 ₽1471 ₽-22%
Лань1887 ₽1471 ₽-22%Традиции и инновации в технологии безалкогольных напитков. Монография | В монографии рассмотрена традиционная технология безалкогольных напитков в историческом и современном аспектах ее развития, сфор...
-
![Общая и санитарная микробиология с техникой микробиологических исследований. Учебное пособие]() Лань4601 ₽3451 ₽-24%
Лань4601 ₽3451 ₽-24%Общая и санитарная микробиология с техникой микробиологических исследований. Учебное пособие | В пособии освещены вопросы общей и санитарной микробиологии. Описаны требования по технике безопасности, ...
-
![Древесностружечные плиты. Огнезащита и технология. Монография]() Лань1669 ₽1128 ₽-32%
Лань1669 ₽1128 ₽-32%Древесностружечные плиты. Огнезащита и технология. Монография | Приведены характеристики ДСП, развитие производства, области применения. Дан анализ их пожарной опасности, рассмотрены стандартные метод...
-
![Технологическое оборудование мясной промышленности. Куттер: учебное пособие для СПО]() Лань648 ₽505 ₽-22%
Лань648 ₽505 ₽-22%Технологическое оборудование мясной промышленности. Куттер: учебное пособие для СПО | В учебном пособии приведен обзор и рассмотрены конструкции куттеров отечественного и зарубежного производства. Дан...
-
![Технология подготовки и реализации кампании по рекламе и связям с общественностью. Учебное пособие]() Лань2713 ₽2115 ₽-22%
Лань2713 ₽2115 ₽-22%Технология подготовки и реализации кампании по рекламе и связям с общественностью. Учебное пособие | В учебном пособии дано комплексное представление о технологии подготовки и реализации кампании по р...
-
![Многоволновые оптические системы связи]() Лань1769 ₽1379 ₽-22%
Лань1769 ₽1379 ₽-22%Многоволновые оптические системы связи | Излагаются принципы построения многоволновых оптических систем связи, оптического мультиплексирования и усиления в многоволновых волоконно-оптических системах ...
-
![Технологии и оборудование современного машиностроения. Учебник]() Лань5899 ₽4599 ₽-22%
Лань5899 ₽4599 ₽-22%Технологии и оборудование современного машиностроения. Учебник | В учебнике приведены основные группы современного многоцелевого оборудования и их технологические возможности. С учетом этого обоснован...
-
![Технология возведения зданий. Учебное пособие]() Лань3303 ₽2575 ₽-22%
Лань3303 ₽2575 ₽-22%Технология возведения зданий. Учебное пособие | Изложены темы, необходимые учащимся для изучения материала по дисциплине "Технология возведения зданий". Курс лекций содержит основные сведения об орган...
-
![Оборудование для ведения тепломассообменных процессов пищевых технологий]() Лань4011 ₽3127 ₽-22%
Лань4011 ₽3127 ₽-22%Оборудование для ведения тепломассообменных процессов пищевых технологий | В учебнике обобщены и систематизированы сведения о состоянии и перспективе технического обеспечения тепломассообменных процес...
-
![Хитиновые материалы в технологии водных биоресурсов. Уч. пособие]() Лань2123 ₽1655 ₽-22%
Лань2123 ₽1655 ₽-22%Хитиновые материалы в технологии водных биоресурсов. Уч. пособие | В учебном пособие приведены сведения о хитиновых материалах, их строении, сырьевых источниках, способах получения и свойствах. Предст...
-
![Технология изготовления лекарственных форм. Жидкие гетерогенные лекарственные формы. Учебное пособие]() Лань549 ₽362 ₽-34%
Лань549 ₽362 ₽-34%Технология изготовления лекарственных форм. Жидкие гетерогенные лекарственные формы. Учебное пособие | Данное пособие содержит краткое изложение теоретических основ изготовления и свойств жидких гетер...
-
![Рецептурный расчет продуктов питания на основе цифровых технологий. Учебное пособие для СПО]() Лань2477 ₽1931 ₽-22%
Лань2477 ₽1931 ₽-22%Рецептурный расчет продуктов питания на основе цифровых технологий. Учебное пособие для СПО | В учебном пособии рассмотрены методы расчета рецептур, и методо-логия оценки сбалансированности продуктов ...
-
![Введение в энергетику. Учебное пособие для СПО]() Лань1569 ₽1106 ₽-29%
Лань1569 ₽1106 ₽-29%Введение в энергетику. Учебное пособие для СПО | В учебном пособии рассматриваются основные законы технической термодинамики, теории тепломассообмена, тепловые схемы, циклы энергетических установок. Р...
-
![Технология производства электронных средств. Учебное пособие]() Лань4719 ₽3679 ₽-22%
Лань4719 ₽3679 ₽-22%Технология производства электронных средств. Учебное пособие | Учебное пособие посвящено вопросам технологии производства электронных средств (ЭС) для радиосвязи, радиовещания, телевидения, радиолокац...
-
![Продовольственная безопасность РФ. Теория и практика питания]() Лань589 ₽459 ₽-22%
Лань589 ₽459 ₽-22%Продовольственная безопасность РФ. Теория и практика питания | В учебном пособии приводятся данные по состоянию производства и потребления сырья и пищевых продуктов, характеризующие продовольственную ...
-
![Сверхкритические флюидные технологии]() Лань6961 ₽5427 ₽-22%
Лань6961 ₽5427 ₽-22%Сверхкритические флюидные технологии | В учебнике изложены начальные представления о термодинамической критической точке и природе критического состояния вещества. Обсуждены физико-химические основы и...
-
![Техника и технологии в животноводстве. Учебник для вузов]() Лань4837 ₽3771 ₽-22%
Лань4837 ₽3771 ₽-22%Техника и технологии в животноводстве. Учебник для вузов | В учебнике рассмотрены приоритетные направления развития животноводства, передовые технологии, системы и способы содержания животных. Изложен...
-
![Технология производства говядины. Учебник]() Лань1533 ₽1195 ₽-22%
Лань1533 ₽1195 ₽-22%Технология производства говядины. Учебник | В учебнике рассмотрены вопросы комплексного решения проблем интенсификации мясного скотоводства. Значительное место отведено вопросам эффективного использов...
-
![Основы моделирования беспроводных сетей. Среда OMNeT++. Учебное пособие]() Лань3067 ₽2391 ₽-22%
Лань3067 ₽2391 ₽-22%Основы моделирования беспроводных сетей. Среда OMNeT++. Учебное пособие | Изложены подходы к построению и исследованию моделей беспроводных сетей простейшей структурной организации. Дается общее предс...
-
![Технология и оборудование для производства и обработки древесных плит. Учебное пособие]() Лань1474 ₽1149 ₽-22%
Лань1474 ₽1149 ₽-22%Технология и оборудование для производства и обработки древесных плит. Учебное пособие | Рассмотрены технология и машины для производства древесно-стружечных плит (ДСтП), плит с ориентированной стружк...
-
![Технология производства продукции животноводства с основами биотехнологии. Учебное пособие]() Лань2713 ₽2115 ₽-22%
Лань2713 ₽2115 ₽-22%Технология производства продукции животноводства с основами биотехнологии. Учебное пособие | Данное учебное пособие знакомит с отечественным и зарубежным опытом интенсификации скотоводства, свиноводст...
-
![Технология производства и переработки продукции свиноводства. Учебник]() Лань3657 ₽2851 ₽-22%
Лань3657 ₽2851 ₽-22%Технология производства и переработки продукции свиноводства. Учебник | В учебнике разработаны вопросы: селекционно-биологические основы разведения свиней; происхождение и биолого-технологические особ...
-
![Базисные методы проектирования и анализа сетей ЭВМ. Учебное пособие]() Лань2595 ₽2023 ₽-22%
Лань2595 ₽2023 ₽-22%Базисные методы проектирования и анализа сетей ЭВМ. Учебное пособие | Рассмотрены задачи выбора структур, комплексного учета распределения функций и производительности сетей ЭВМ. Изложены методики, по...
-
![Информационные технологии проектирования радиоэлектронных средств. Учебное пособие]() Лань3067 ₽2391 ₽-22%
Лань3067 ₽2391 ₽-22%Информационные технологии проектирования радиоэлектронных средств. Учебное пособие | Приведены основные понятия, определения и классификация информационных технологий и систем. Рассмотрены основные по...
-
![Технология разведения и содержания свиней. Учебн. пос. 1-е изд.]() Лань2005 ₽1563 ₽-22%
Лань2005 ₽1563 ₽-22%Технология разведения и содержания свиней. Учебн. пос. 1-е изд. | В настоящем учебном пособии излагаются актуальные проблемы свиноводства, наиболее интересующие специалистов в современных условиях. За...
-
![Управление качеством программного продукта. Учебное пособие для СПО]() Лань1710 ₽1333 ₽-22%
Лань1710 ₽1333 ₽-22%Управление качеством программного продукта. Учебное пособие для СПО | В учебном пособии рассматривается одна из важнейших проблем информационного общества — проблема качества в сфере информационных те...
-
![Стандартизация технология переработки и хранения продукции животноводства. Учебн. пос. 2-е изд. перераб. и доп.]() Лань3067 ₽2300 ₽-25%
Лань3067 ₽2300 ₽-25%Стандартизация технология переработки и хранения продукции животноводства. Учебн. пос. 2-е изд. перераб. и доп. | Учебное пособие включает разделы: стандартизация и ее роль в повышении качества продук...
-
![Практикум по технологии отрасли (технология хлебобулочных изделий): Уч.пособие]() Лань2595 ₽2023 ₽-22%
Лань2595 ₽2023 ₽-22%Практикум по технологии отрасли (технология хлебобулочных изделий): Уч.пособие | Учебное пособие разработано в соответствии с требованиями основной образовательной программы подготовки бакалавров по н...
-
![Технология лекарственных форм: примеры экстемпоральной рецептуры на основе "старого" аптечного блокнота. Учебное пособие]() Лань969 ₽646 ₽-33%
Лань969 ₽646 ₽-33%Технология лекарственных форм: примеры экстемпоральной рецептуры на основе "старого" аптечного блокнота. Учебное пособие | Данное пособие представляет собой текстовое отображение рукописного рабочего ...
-
![Компьютерные технологий в машиностроении. Практикум (+CD). Учебное пособие]() Лань2713 ₽2115 ₽-22%
Лань2713 ₽2115 ₽-22%Компьютерные технологий в машиностроении. Практикум (+CD). Учебное пособие | В учебном пособии приведена методика выполнения лабораторных и практических работ компьютерного построении 3D-моделей и чер...
-
![Распределенные информационные системы. Учебник]() Лань2477 ₽1931 ₽-22%
Лань2477 ₽1931 ₽-22%Распределенные информационные системы. Учебник | Учебник создан в соответствии с Федеральным государственным образовательным стандартом по направлению магистратуры «Информационные системы и технологии...
-
![Технологическое оборудование переработки молока: учебник для СПО]() Лань3067 ₽2391 ₽-22%
Лань3067 ₽2391 ₽-22%Технологическое оборудование переработки молока: учебник для СПО | В учебнике описано основное технологическое оборудование, применяемое для переработки молока. Приведены классификация технологическог...
-
![Функциональное питание. Учебное пособие]() Лань2241 ₽1747 ₽-22%
Лань2241 ₽1747 ₽-22%Функциональное питание. Учебное пособие | В учебном пособии рассмотрены основные положения дисциплины «Функциональное питание». Дано понятие о функциональном питании, функциональных пищевых продуктах,...
-
![Курсовое проектирование для специальностей "Технология деревообработки", "Технология комплексной переработки древесины". Учебное пособие]() Лань1061 ₽827 ₽-22%
Лань1061 ₽827 ₽-22%Курсовое проектирование для специальностей "Технология деревообработки", "Технология комплексной переработки древесины". Учебное пособие | В пособии изложен порядок выполнения и оформления курсового п...
-
![Гидротехнические сооружения морских портов. Учебное пособие для вузов, 3-е изд.]() Лань5620 ₽3934 ₽-30%
Лань5620 ₽3934 ₽-30%Гидротехнические сооружения морских портов. Учебное пособие для вузов, 3-е изд. | Материал книги содержит примеры компоновки морских портов, построенных в последние десятилетия в РФ и за рубежом, в то...
-
![Химия и технология полимеров. Получение полимеров методами полимеризации. Лабораторный практикум]() Лань2409 ₽1700 ₽-29%
Лань2409 ₽1700 ₽-29%Химия и технология полимеров. Получение полимеров методами полимеризации. Лабораторный практикум | Учебное пособие представляет собой руководство для выполнения лабораторных работ. В нем содержится ин...